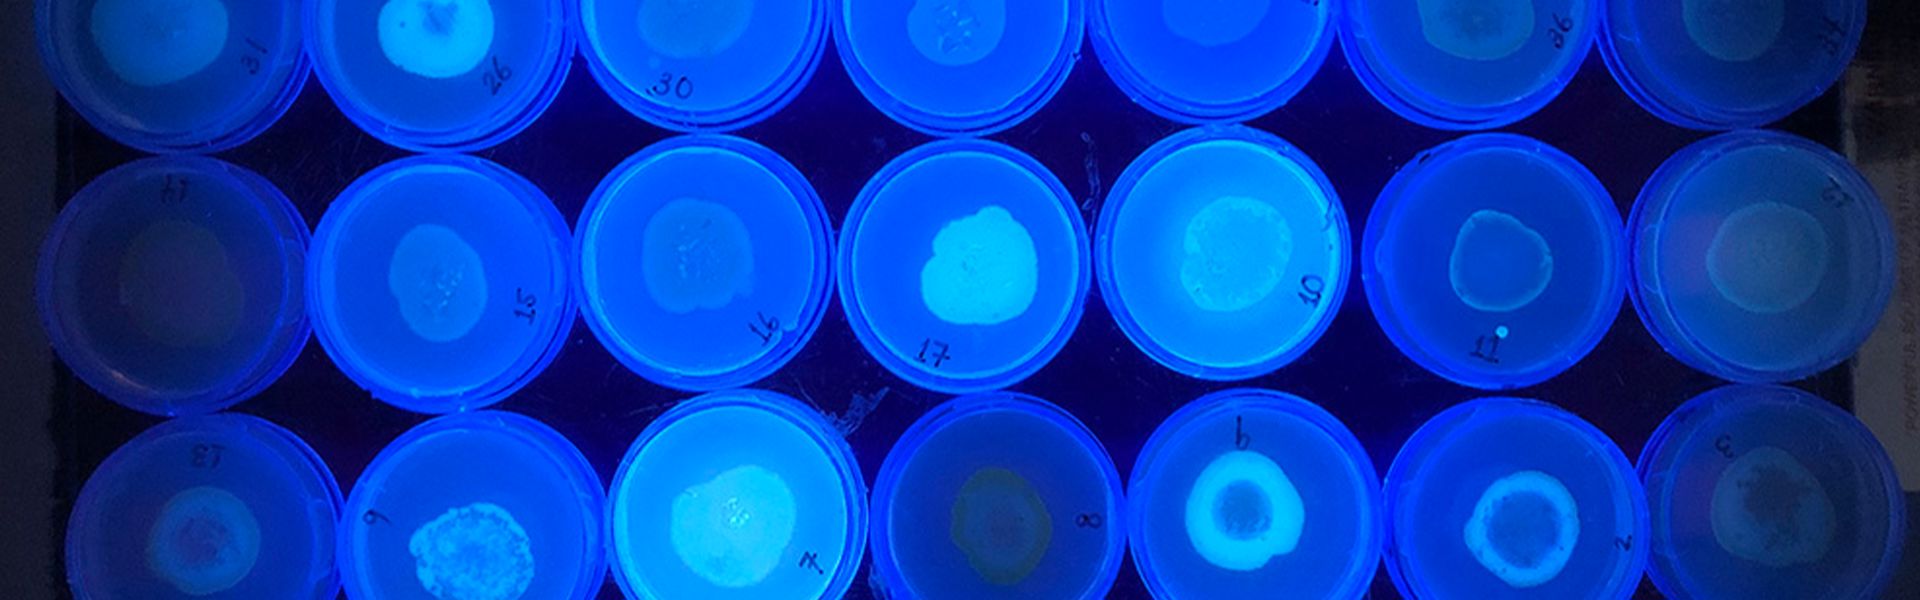
blue plates

Program overview
The Robert W. Finberg Physician-Scientist Training Program in the Department of Medicine at UMass Chan Medical School trains the next generation of physician-scientists. UMass Chan Medical School is a preeminent research institution in the world, home to two Nobel Laureates (including Victor Ambros, PhD, the winner of the 2024 Nobel Prize in Physiology or Medicine), a Lasker Award winner, a Breakthrough Prize winner, eight members of the National Academy of Sciences, four Howard Hughes Medical Institute investigators, and hundreds of gifted PhD, MD/PhD, and MD scientists that are making transformative discoveries about health and disease. The Finberg Physician-Scientist Training Program allows internal medicine residents at UMass Chan to tap an enormous wealth of expertise to launch their careers as independent physician-scientists.
Our comprehensive training in clinical medicine and biomedical research supports internal medicine residents at all stages of their professional journey, from initial training as a resident to appointment as tenure-track faculty.
Learn more about our program
Meet our leadership team

Contact us:
Questions may be directed to the Finberg Physician-Scientist Training Program: FinbergPSTP@umassmed.edu